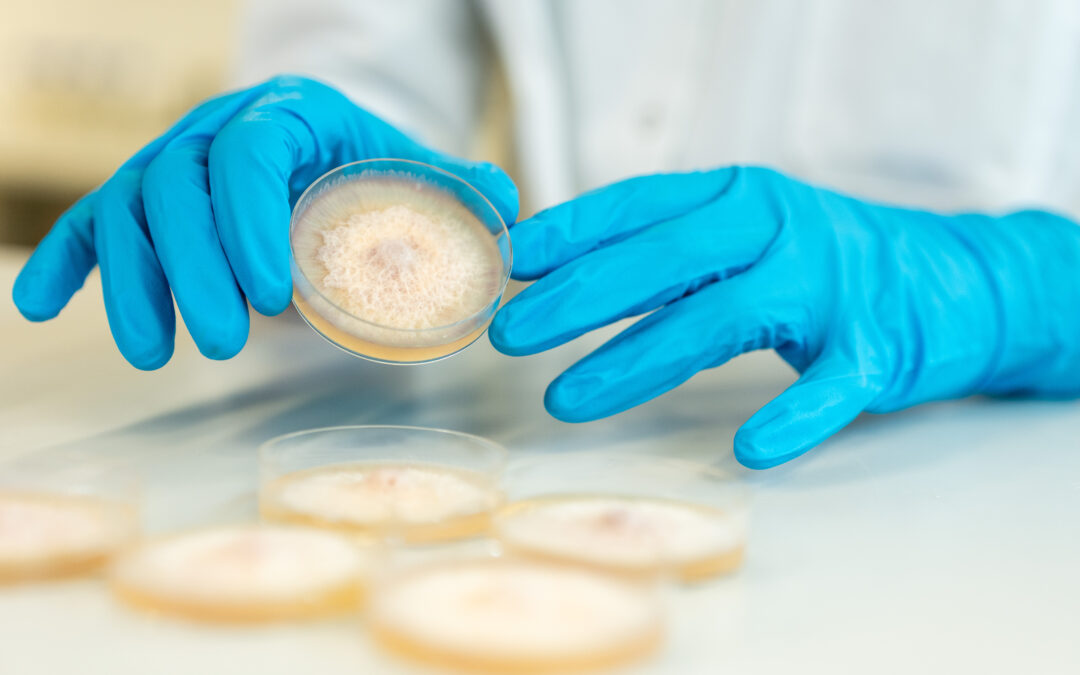

Tieto gewinnt Microsoft Visionary Award 2025 für EVN-Datenprojekt
Bei der Microsoft Partner Award-Gala im Wiener Palais Ferstel wurde der Tech-Consulting-Dienstleister Tieto (vormals Tietoevry) mit dem „Microsoft Partner of the Year Visionary Award 2025“ in der Kategorie Innovation ausgezeichnet.
AIT und Takeda ausgezeichnet für NEFI-Projekt AHEAD
AIT und Takeda erhalten den DECA Award 2025 Industrie für das NEFI-Projekt AHEAD und seinen innovativen Hochtemperatur-Wärmepumpendemonstrator.
Technology Impact Summit debattiert digitale Souveränität
Zwischen Innovation und Überregulierung: Wie Europa seine technologische Unabhängigkeit gestaltet.
Forschung
Zersiedelung bedroht bis 2050 den Zugang zu sauberem Wasser
Studie von CSH und Weltbank: Zersiedelung könnte bis 2050 Hunderten Millionen Menschen den Zugang zu Wasser und Abwasser erschweren.
Grete Rehor-Preis 2025 für AIT-Expertin Anna Huditz
Auszeichnung in der Kategorie „MINT und Digitalisierung“ für herausragende Leistungen im Infrastruktur- und Verkehrsmanagement sowie ihr Engagement als Role Model für Frauen in Technik und Forschung.
Warum manche Gesellschaften trotz enormer Krisen nicht untergingen
Im Laufe der Geschichte haben Krisen oft zum Zusammenbruch ganzer...
Wirtschaft
Wettlauf um Talente nimmt Fahrt auf: Tech-Arbeitskräfte werden ins Ausland abgeworben
Laut eines neuen Berichts werben Hightech-Unternehmen wechselseitig um Arbeitskräfte, während Nationen im Wettlauf um Selbstversorgung und Spitzenkräfte Geld in MINT-Branchen investieren.
Energy Launchpad geht an den Start
In Wien startete das Energy Launchpad, eine europäische Plattform, die Startups, Forschung und Industrie für gemeinsame Open-Innovation-Lösungen zur Energietransformation vernetzt.
Kwizda Agro bringt für britisches Bio-Tech-Unternehmen Pilze zur Marktreife
Formulierungskompetenz als Schlüssel für biologische Produktentwicklung
Bildung
20 Jahre Lange Nacht der Forschung: Salzburg feiert Jubiläum mit 11 Standorten
Am 24. April 2026 öffnet die Wissenschaft ihre Türen – zum 10. Mal in Salzburg
TMW-Sonderausstellung „Im Bann der Bahn. 200 Jahre Eisenbahn.“
Mehr als 50 imposante Eisenbahnmodelle, das älteste aus dem Jahr 1843, erzählen in der neuen Sonderausstellung im Technischen Museum (TMW) von der Entwicklung der Dampflok bis zu Schnellzuglokomotiven.
Zukunft gestalten: Innovativ mit Papier, Schilf und Hanf
Im TMW präsentiert der Innovation Corner in Kooperation mit der Austria Wirtschaftsservice Gesellschaft mbH (aws) zukunftsweisende Projekte, die im Sinne der Kreislaufwirtschaft entwickelt und umgesetzt wurden. Denn um mit begrenzten Rohstoffen so umzugehen, dass unser Lebensstandard auch in Zukunft gehalten werden kann, muss ein Produkt von Beginn an kreislauffähig gedacht werden.
Politik
Cybersecurity: Klare Verantwortlichkeiten gefordert
ONEKEY IoT & OT Cybersecurity Report 2025: Der Cyber Resilience Act (CRA) stellt Unternehmen mit seiner abteilungs- und funktionsübergreifenden Wirkung vor Herausforderungen, wenn es um die Verantwortlichkeiten geht.
70. Jahre Deutsche Handelskammer in Österreich – Jubiläumsfeier im Palais Ferstel
Verkehrsminister Peter Hanke: Österreich und Deutschland müssen starke innovative und wettbewerbsfähige Standorte bleiben. Sie dürfen sich aber nicht auf Erfolgen ausruhen.
Digitaler Humanismus in der Praxis Award 2026
Technologische Innovation im Einklang mit gesellschaftlichen Werten
Nachhaltigkeit
AIT und Takeda ausgezeichnet für NEFI-Projekt AHEAD
AIT und Takeda erhalten den DECA Award 2025 Industrie für das NEFI-Projekt AHEAD und seinen innovativen Hochtemperatur-Wärmepumpendemonstrator.
Tieto gewinnt Microsoft Visionary Award 2025 für EVN-Datenprojekt
Bei der Microsoft Partner Award-Gala im Wiener Palais Ferstel wurde der Tech-Consulting-Dienstleister Tieto (vormals Tietoevry) mit dem „Microsoft Partner of the Year Visionary Award 2025“ in der Kategorie Innovation ausgezeichnet.
Neue Prüfstelle für Treibhausgas-Bilanzierung von Produkten
Quality Austria Certification bietet ab sofort akkreditierte Verifizierung von Product Carbon Footprints nach ISO 14067 an.
Künstliche Intelligenz
Technology Impact Summit debattiert digitale Souveränität
Zwischen Innovation und Überregulierung: Wie Europa seine technologische Unabhängigkeit gestaltet.
HR neu gedacht: Wolkenrot und UnchAIned entwickeln KI-Agentin „Jeannie“
Neuer KI-gestützter Prozess bringt Personalabteilungen bis zu 80 Prozent Zeitersparnis beim On- und Offboarding und zeigt, wie Mensch und Maschine im HR-Bereich künftig zusammenarbeiten.
Weltkonferenz zu Künstlicher Intelligenz und Kybernetik ist in Wien
Von 5. bis 8. Oktober 2025 wird Wien zum globalen Zentrum für Künstliche Intelligenz, Kybernetik und Systemwissenschaften. Die IEEE Systems, Man, and Cybernetics Conference (IEEE SMC 2025) zählt zu den weltweit bedeutendsten Plattformen für interdisziplinären Austausch zu Mensch-Maschine-Interaktion, Systemtechnik und KI-Forschung.